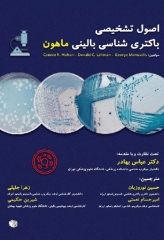
اصول تشخیصی باکتری شناسی بالینی ماهون 2015

دسته بندی ها
دستههای مشترک
آزمونهای علوم پزشکی
- کاردانی به کارشناسی
- ارشد وزارت بهداشت
- دکترای وزارت بهداشت
- آزمون MHLE و آیلتس
- آزمون علومپایه پزشکی و دندانپزشکی
- آزمون پرانترنی (پیشکارورزی)
- پذیرش دستیار تخصصی
- پذیرش دستیار فوق تخصصی پزشکی
- ارتقاء/گواهینامه و دانشنامه تخصصی (بورد)
- صلاحیت حرفهای گروه پرستاری
- آزمون لیسانس به پزشکی همه دستهبندیهای آزمونهای علوم پزشکی
دستههای پرطرفدار